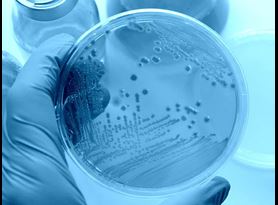

You need confidence in the ability of your disinfectants to eliminate microbial contaminants in your facility. With our expertise in performing Disinfectant Efficacy Testing (DETs), our experienced, consultative team will partner with you to ensure your critical aseptic environment is disinfected effectively using the most appropriate solutions and protocols. Disinfect with confidence and clarity – partner with Element for data-driven proof of efficacy.
Disinfectant efficacy tests for aseptic environments
Disinfectant Efficacy Testing (DET) formally evaluates the efficacy and suitability of disinfectants used to eliminate microorganisms and viruses on the various surface types and components within an aseptic/controlled environment. Whether you are a manufacturer of pharmaceuticals, a compounding pharmacy, or operate in a controlled environment, it is critical to know that your disinfectants are effective against microorganisms and pathogens. For regulatory purposes, it is important to have evidence of the efficacy of those disinfectants.
Element’s testing complies with USP <1072> Disinfectants and Antiseptics, and partners with you to help you develop an effective cleaning/disinfection regimen for your controlled spaces. We customize testing to conform to your facility’s surfaces, while also testing the surfaces outlined in USP <1072>. Our lab will test your chosen disinfectants against the USP standard organisms, on specified materials, with the option to use your disinfectant application methods. As mentioned, we also customize testing to include materials specific to your facility that are not included in the USP. We test the variety of microorganisms listed in <1072> as well tailor testing to organisms isolated from your facility. Our disinfectant efficacy studies evaluate effectiveness while providing you with the valuable data needed to establish your contamination control strategy.
Key Benefits of Disinfectant Efficacy Testing with Element
- Multi-level testing all with one provider - Element provides a plethora of services related (but not limited to) GMPs and compounding facilities. Because we are experts at a variety of tests, we can test at different levels of your contamination control strategy. Element can provide the Environmental Monitoring services necessary to recover organism from your facility. We can sample, isolate, identify, and harvest organisms for your DET all in one place. In summary, we can provide the in vitro efficacy testing, in situ environmental monitoring, and routine environmental monitoring needed to holistically complete your disinfectant validation.
- Aggressive testing schedules - Element understands that disinfectant studies can be a bottleneck in getting your facility up and running with confidence. With that understanding, we work with you on timelines to meet your facility’s goals. Because we understand communication is key as a study progresses, we provide regular communication on the testing, with notifications of any test failures. With analysts devoted to disinfectant studies, we can provide you with service that aims for timely completion of your study – whether the project is big or small.
- Custom protocols tailored to your needs - Each facility, no matter its size, comes with its own peculiarities and intricacies. We can work with you to customize a testing protocol that fits your needs, whether it’s the type of disinfectant you want to challenge, the surfaces you want to test, the contact time you want to use, the organisms you want to test, or even the method of disinfection. Working with Element will ensure your disinfectant study is inclusive and comprehensive. We can customize your protocol as much as needed, or we can provide a standardized protocol based on industry guidelines.
Disinfectant qualification test methods
Disinfectant Efficacy Testing for Bacteria and Mold (vegetative and spore forming)
Representative surfaces found in the GMP manufacturing facility are inoculated with test organisms utilized in the manufacturing production plus any routine microbiological contaminants isolated by the facility during the manufacturing process. The surfaces are disinfected using the disinfection practices commonly used at the facility. Following treatment, the surfaces are assayed for surviving organism. The level of reduction deemed necessary for appropriate disinfection is determined by the GMP facility performing the qualification testing.
Disinfectant Efficacy Testing for Antiviral Activity
Representative surfaces found in the GMP manufacturing facility are inoculated with test viruses utilized in the manufacturing production plus any routine viral contaminants isolated by the facility during the manufacturing process. The surfaces are disinfected using the disinfection practices commonly used at the facility. Following treatment, the surfaces are assayed for surviving viruses by an assay method specific for the test virus. The level of reduction deemed necessary for appropriate disinfection is determined by the GMP facility performing the qualification testing.
Our range of services offered:
- Guidance on DET study design
- Customized study design
- Custom methods - wet contact, wipe, mop
- Development of robust Disinfectant Protocol
- Recovery studies on custom surface
- Neutralization of disinfectant
- Efficacy studies - surface disinfectant organism vs. contact time
- Customized suspension preparation for in-house isolates - recovered from facility
- Kill time studies - dilution
- Customized reporting
The Element advantage
Partner with Element today to ensure the safety of aseptic, sterile, and controlled environments with our comprehensive disinfection qualification services. To learn more about our disinfection qualification services, about additional methods available or to speak with an expert, get in touch with us today.
Learn more

Antimicrobial Microbiology Testing
We have extensive experience performing efficacy testing to meet submission requirements for regulatory bodies worldwide such as: the EPA, Health Canada, Australian Therapeutic Goods Administration (TGA), European Chemicals Agency, and the FDA.

Environmental Monitoring
Our Environmental Monitoring programs allow pharmaceutical manufacturers and compounders to measure and monitor cleanliness and contamination levels within their facilities.

Pharmaceutical Testing
Element’s pharmaceutical laboratories provide specialist pharmaceutical testing services, including chemical, physical, microbial, and stability testing on a vast array of products, from raw materials to finished products.
Antimicrobial Testing
With more than 30 years of experience, we are the premier contract antimicrobial testing laboratory and expert partner to the developers, manufacturers and users of antimicrobial pesticide and biocide products.